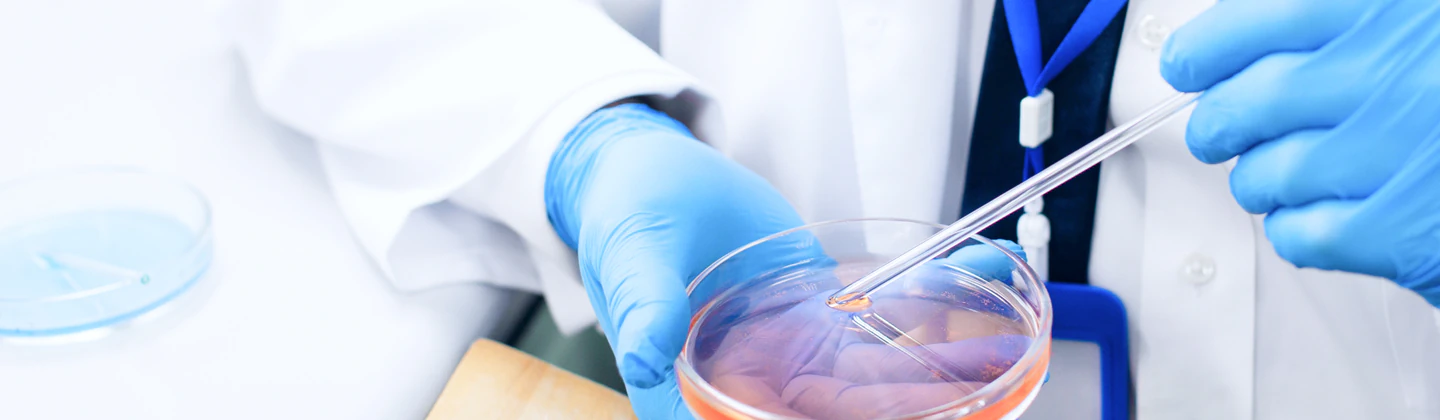
Гепатолог в Красноярске

Гепатология – это область медицины, посвященная диагностике, лечению и профилактике заболеваний печени, желчного пузыря и желчевыводящих путей. В клинике «Дуэт Клиник» в Красноярске прием ведут опытные врачи-гепатологи, которые помогут вам сохранить здоровье одной из важнейших систем организма.
Когда необходима консультация гепатолога?
Заболевания печени часто длительное время протекают бессимптомно. Обратиться к специалисту рекомендуется при появлении следующих признаков:
- Дискомфорт, тяжесть или боль в правом подреберье.
- Пожелтение кожи, склер глаз (желтуха).
- Постоянная слабость, утомляемость без явных причин.
- Тошнота, горечь во рту, нарушения аппетита.
- Изменение цвета мочи (потемнение) и стула (обесцвечивание).
- Появление сосудистых звездочек на коже, кожный зуд.
- Плановое наблюдение при уже установленных диагнозах (гепатит, жировая болезнь печени, цирроз).
Какие заболевания диагностирует и лечит гепатолог?
- Вирусные гепатиты (A, B, C, D, E).
- Неалкогольная и алкогольная жировая болезнь печени.
- Токсические и лекарственные поражения печени.
- Аутоиммунные заболевания (аутоиммунный гепатит, первичный билиарный холангит).
- Желчнокаменная болезнь, дискинезия желчевыводящих путей, холецистит.
- Цирроз печени и его осложнения.
- Наследственные заболевания (гемохроматоз, болезнь Вильсона).
Как проходит прием в «Дуэт Клиник»?
- Первичная консультация: Детальный сбор анамнеза, анализ жалоб и имеющихся медицинских документов.
- Осмотр: Врач проводит физикальный осмотр, включая пальпацию области печени.
- Диагностический план: На основании первичного приема гепатолог составляет индивидуальный план обследования для точной постановки диагноза.
- Назначение лечения: После получения всех данных разрабатывается комплексная терапия, включающая медикаментозное лечение, диету и коррекцию образа жизни.
- Контроль и наблюдение: Регулярные осмотры и контроль анализов для оценки эффективности лечения и профилактики осложнений.
Преимущества обращения в «Дуэт Клиник»
- Прием ведут высококвалифицированные врачи с большим опытом работы в гепатологии.
- Индивидуальный подход к каждому пациенту и разработка персональной схемы лечения.
- Возможность пройти комплексную диагностику на современном оборудовании.
- Комфортная атмосфера и внимательное отношение медицинского персонала.
- Соблюдение современных клинических рекомендаций и протоколов лечения.
Здоровье печени – основа вашего долголетия и качества жизни. Доверьте диагностику и лечение заболеваний гепатобилиарной системы профессионалам клиники «Дуэт Клиник» в Красноярске.